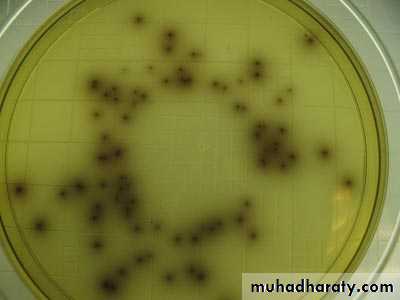
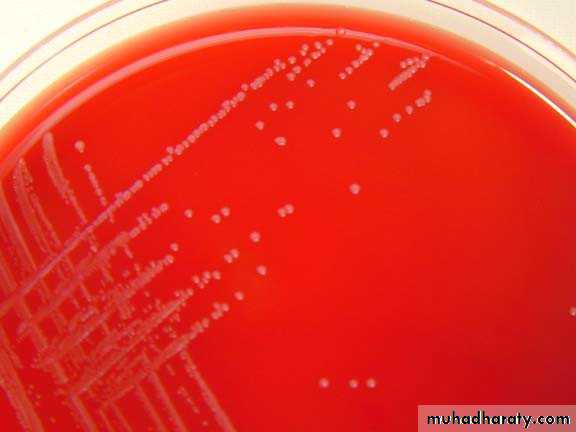

LISTERIA Listeria monocytogenes is a Gram-positive bacterium, in the division Firmicutes, named after Joseph Lister. Its ability to grow at temperatures as low as 0 °C permits multiplication at typical refrigeration temperatures, greatly increasing its ability to evade control in human foodstuffs. Motile via flagella at 30 °C and below, but usually not at 37 °C,[4] L. monocytogenes can instead move within eukaryotic cells by explosive polymerization of actin filaments (known as comet tails or actin
rockets).
It is a facultative anaerobic bacterium, capable of surviving in the presence or absence of oxygen
Pathogenecity
Invasive infection by L. monocytogenes causes the disease listeriosis. When the infection is not invasive, any illness as a consequence of infection is termed febrile gastroenteritis. The manifestations of listeriosis include septicemia,[19]meningitis (or meningoencephalitis),[19] encephalitis,[20] corneal ulcer,[21]pneumonia,[22] and intrauterine or cervical infections in pregnant women, which may result in spontaneous abortion (second to third trimester) or stillbirth. Surviving neonates of fetomaternal listeriosis may suffer granulomatosis infantiseptica — pyogenic granulomas distributed over the whole body — and may suffer from physical retardation. Influenza-like symptoms, including persistent fever, usually precede the onset of the aforementioned disorders. Gastrointestinal symptoms, such as nausea, vomiting, and diarrhea, may precede more serious forms of listeriosis or may be the only symptoms expressed. lL. monocytogenes is unique among Gram-positive bacteria in that it might possess lipopolysaccharide,[23] which serves as an endotoxin
Later, it was found to not be a true endotoxin. Listeria cell walls consistently
contain lipoteichoic acids
These lipoteichoic acids resemble the lipopolysaccharides of Gram-negative bacteria in both structure and function, being the only amphipathic polymers at the cell surface.[24][25]
Diagnosis
The Anton test is used in the identification of L. monocytogenes; instillation of aculture into the conjunctival sac of a rabbit or guinea pig causes severe keratoconjunctivitis within 24 hours.[32][33]
Listeria species grow on media such as Mueller-Hinton agar. Identification is enhanced if the primary cultures are done on agar containing sheep blood, because the characteristic small zone of hemolysis can be observed around and under colonies.
Isolation can be enhanced if the tissue is kept at 4 °C for some days before inoculation into bacteriologic media. The organism is a facultative anaerobe and is catalase-positive and motile. Listeria produces acid, but not gas, in a variety of carbohydrates.[34] The motility at room temperature and hemolysin production are primary findings that help differentiate listeria from coryneform bacteria.
Colonies of typical L. monocytogenes as they appear when grown on Listeria-selective agar
Listeria monocytogenes hemolysisColonies of Listeria monocytogenes on blood agar. Cultivation 48 hours, 37°C. Listeria monocytogenes is beta-hemolytic on sheep blood agar plates but often produce only narrow zones of hemolysis that frequently do not extend much beyond the edge of the colonies.